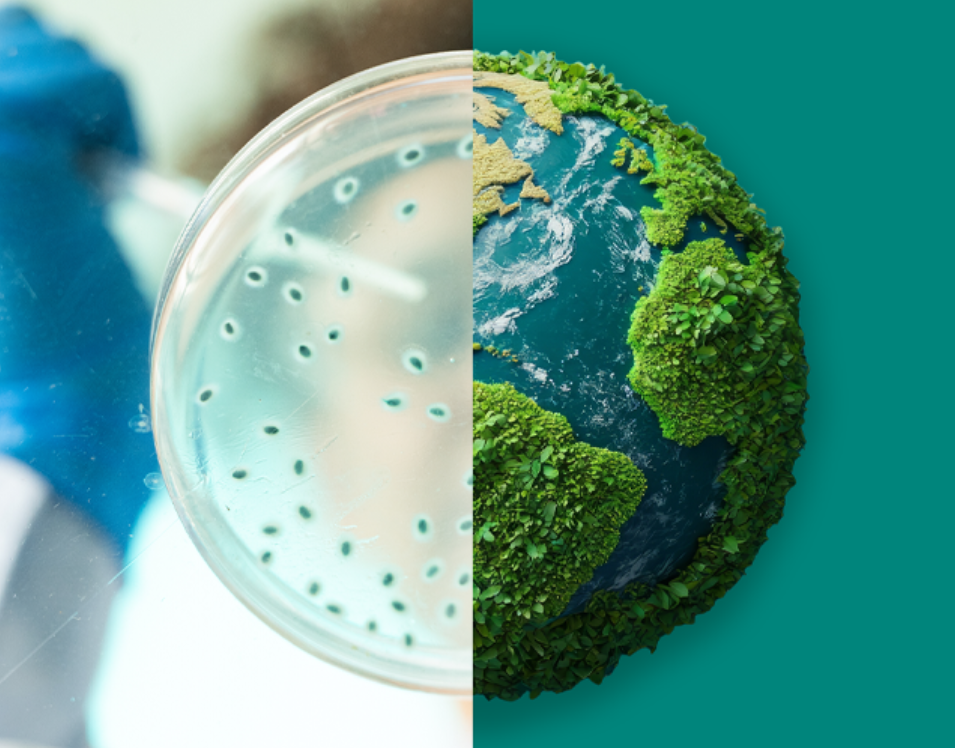

Sustainability
We operate responsibly every day to improve human and animal health, now and in the future.
Sustainability is core to how we do business
From expanding access to care to advancing environmental goals, our Purpose for Progress: MSD Impact Report 2024/2025 shows how our company is creating measurable impact — for people, communities and the planet. The name reinforces how our purpose serves as a compass and guides us in our every endeavor. Because progress doesn’t just happen. It’s built — by people, with purpose.
Watch: Our company's impact
AU-NON-00725 Last updated December 2025
